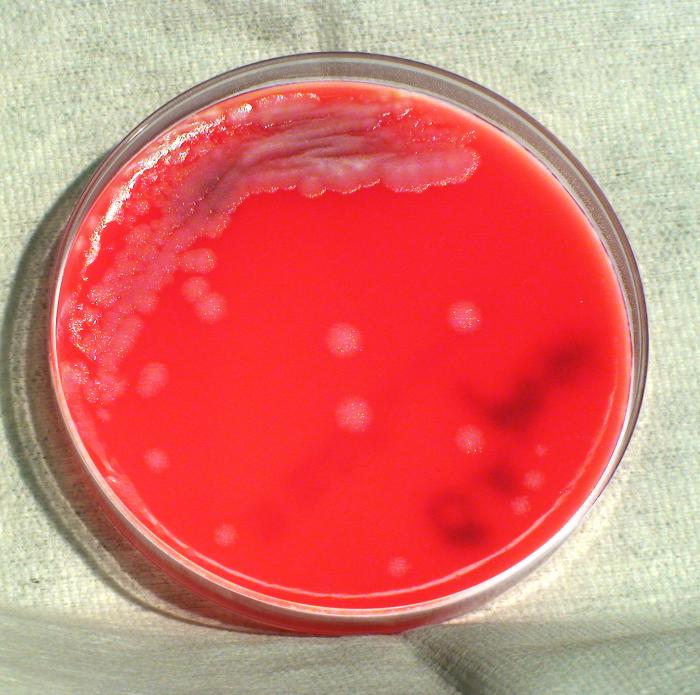

Бактериоскопия: Исследование сибирской язвы

Раздел: Снимки мастерства